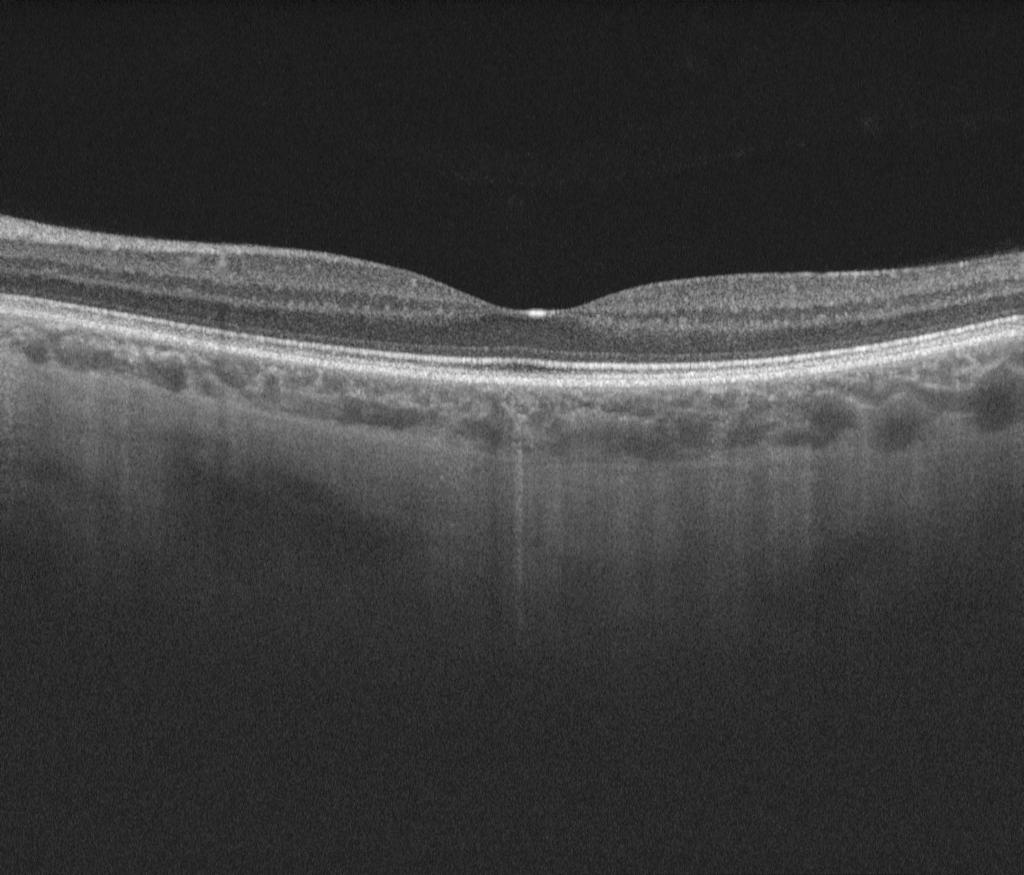

Well-established in Taunton
Private Retinal Treatments at Nuffield Health Taunton Hospital
Mr Jonathan Park in addition to providing bespoke cataract surgery with premium lens implants is also a retinal specialist providing care for macular problems and retinal surgery
What retinal treatments are available privately?
Having completed an internationally respected sub-speciality retinal fellowship, I have the required knowledge to treat you for a wide range of medical and surgical retinal and macular problems privately. These include clinic reviews and intra-vitreal eye injections of various drugs for age-related macular degeneration (AMD), diabetic macular oedema (DMO) and retinal vein occlusion (RVO).
I can also provide private retinal surgery such as vitrectomy for macular hole, epiretinal membrane, vitreomacular traction, vitreous haemorrhage and floaters.

Why choose private retinal treatments?
Most patients choose to have their retinal or macular treatment privately for the same reasons as to why patients choose to have private cataract surgery. Retinal conditions often require frequent reviews and private treatments ensure a dependable aftercare. With the same consultant, it assures continuity of care and in a timely fashion.

Private retinal treatments without insurance
You can always have a private retinal treatment without any insurance. This would mean that you are a "self-paying" patient. If you have insurance, your insurance company might either pay all or share half the fees with you. This depends on the company and the type of insurance policy. My secretary can inform you of the prices, and work with you and the insurance company to clarify costs (please see contact page).
I am registered to work with the following private medical insurance providers:
Aviva Health, AXA PPP Healthcare, Bupa, Cigna, CS Healthcare, Exeter Family Friendly, Healix, Vitality Health (Pru Health), Simplyhealth and WPA.
Many high street optometrists and opticians now use retinal scans (OCT machines)
to check the health of the back of your eye (some example images are shown below). Mr Jonathan Park specialises in the review and management of these retinal scans.
Please call my private secretary or the Nuffield Health, Taunton Hospital
07714 676 720 or 01823 286 991
to book a consultation, or email
linda.meek@nuffieldhealthpartners.com